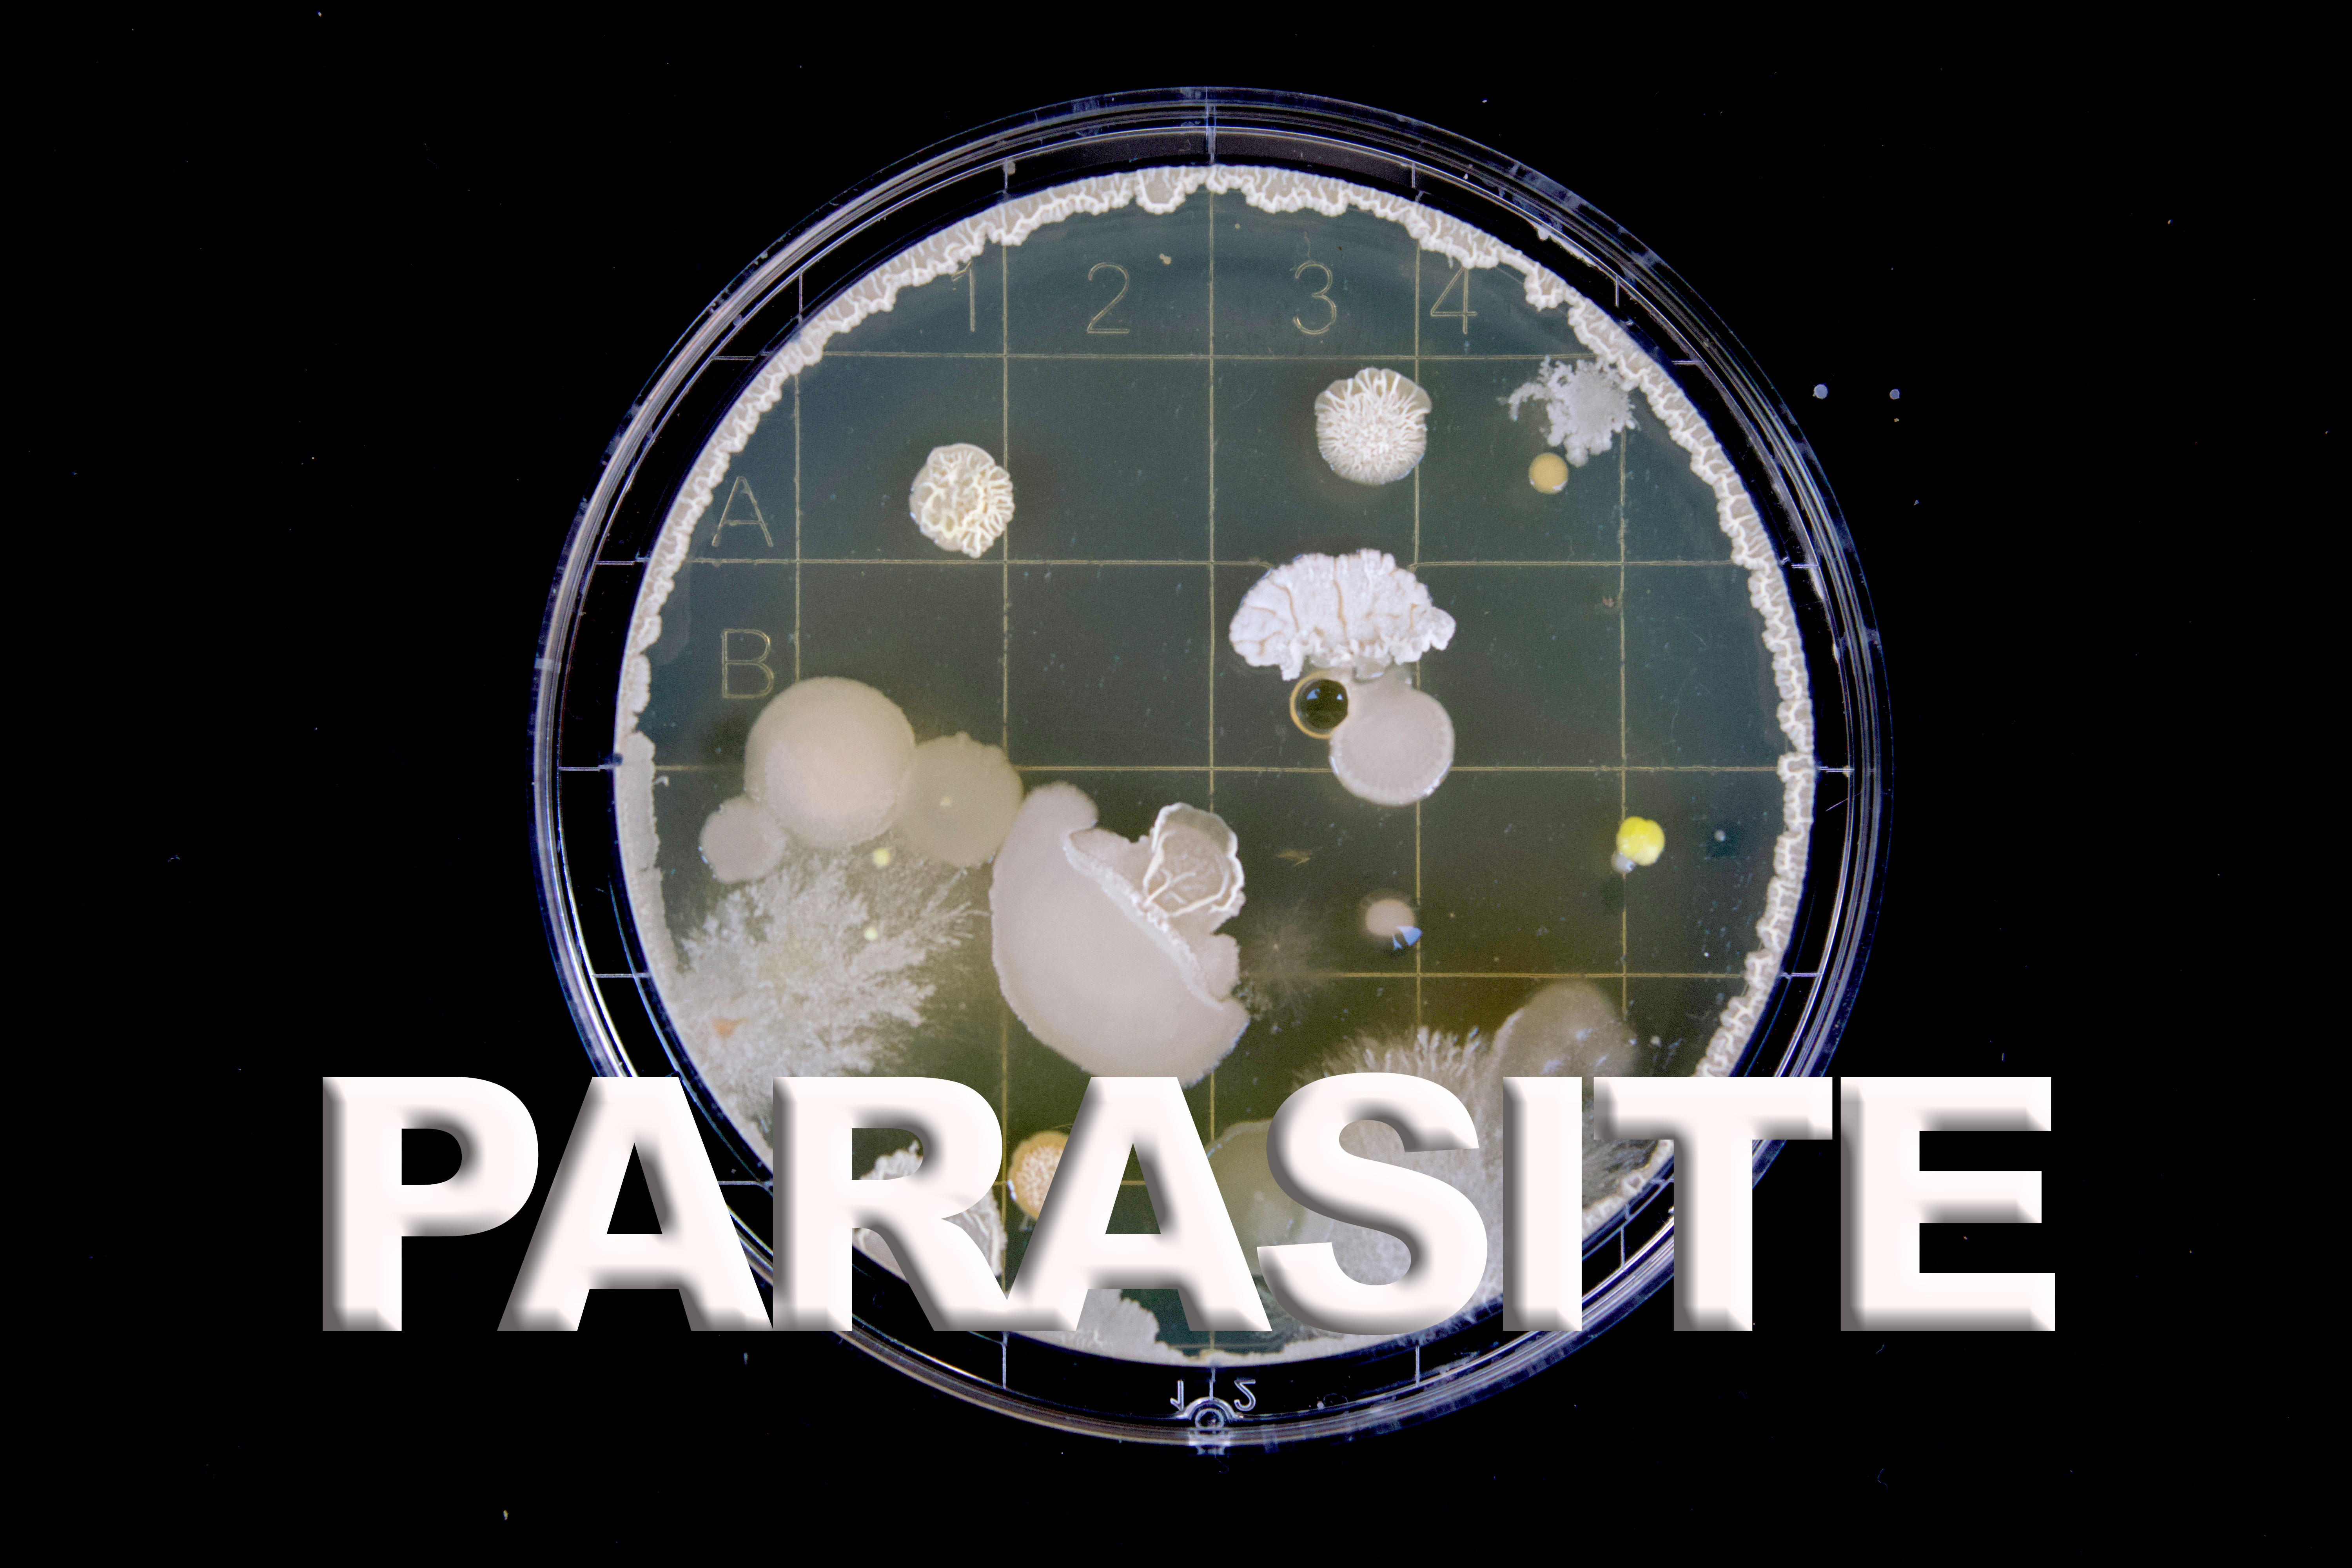
featured

Lismar Camacho (40)
Me gusta el arte, dibujar a mano y el arte digital
280 followers264 posts154 following3 HP
Blacklisted UsersMuted UsersFollowed BlacklistsFollowed Muted Lists
Blacklisted UsersMuted UsersFollowed BlacklistsFollowed Muted Lists
lismarcamacho.wordpress.com Joined April 2018 Active 6 years ago